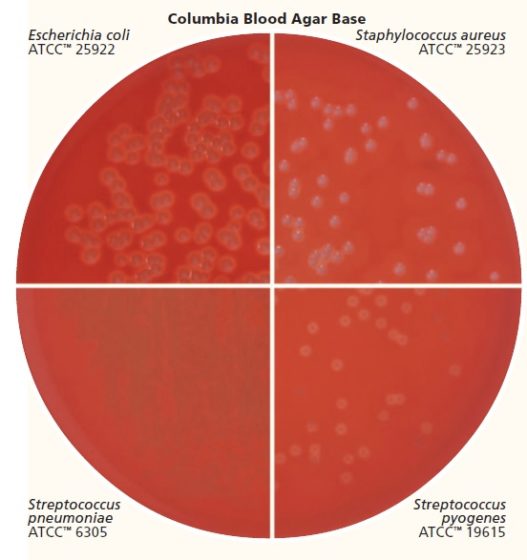
Sheep Columbia Blood Agar Plates (14x1) CA002 At Rs 700 In Delhi - ID: 2019781 - Foto 9

Sheep Columbia Blood Agar Plates (14x1) CA002 At Rs 700 In Delhi - ID: 2019781
Disponibile
Disponibile
€ 2
AGGIUNGI AL CARRELLO
Consegna
- Corriere espressoda martedì 3 febbraioGRATIS
Venduto e spedito da ePRICE

Altri 12 venditori a partire da € 2
- Informazioni legali
- Ne hai uno da vendere?
- 467433
- 57377616555
Pensati per Te
Prodotti simili
Descrizione
Per ulteriori dettagli vedi l'inserzione., Type: Agar, Expiry Date: N/A, MPN: N/A, Brand: Unbranded Columbia Blood Agar Lab Results Sheep Columbia Blood Agar Plates (14x1) CA002 At Rs 700 In Delhi - ID: 2019781 Columbia Uomo Scarpe Columbia Agar at best price in Bhiwadi by Titan Biotech Limited | ID: 2082082673 Labels & Certifications: Store Cold, EAN: Does not apply Our blood agar plates are specially designed with defibrinated animal blood, making them ideal for culturing streptococcus, staphylococcus, and more. With a hemolysis test capability, these plates offer comprehensive analysis possibilities Biomerieux Columbia Agar % Horse Blood at best price in New DelhiCaratteristiche e scheda tecnica
Caratteristiche principali
- EAN9611137009111
Recensioni
2026-02-02 | asuyna3